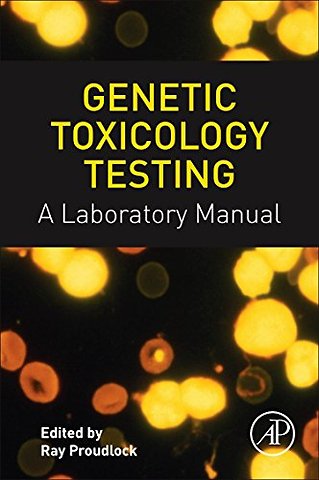

Genetic Toxicology Testing
A Laboratory Manual
Samenvatting
Genetic Toxicology Testing: A Laboratory Manual presents a practical guide to genetic toxicology testing of chemicals in a GLP environment. The most commonly used assays are described, from laboratory and test design to results analysis. In a methodical manner, individual test methods are described step-by-step, along with equipment, suggested suppliers, recipes for reagents, and evaluation criteria.
An invaluable resource in the lab, this book will help to troubleshoot any assay problems you may encounter to optimise quality and efficiency in your genetic toxicology tests. Genetic Toxicology Testing: A Laboratory Manual is an essential reference for those new to the genetic toxicology laboratory, or anyone involved in setting up their own.